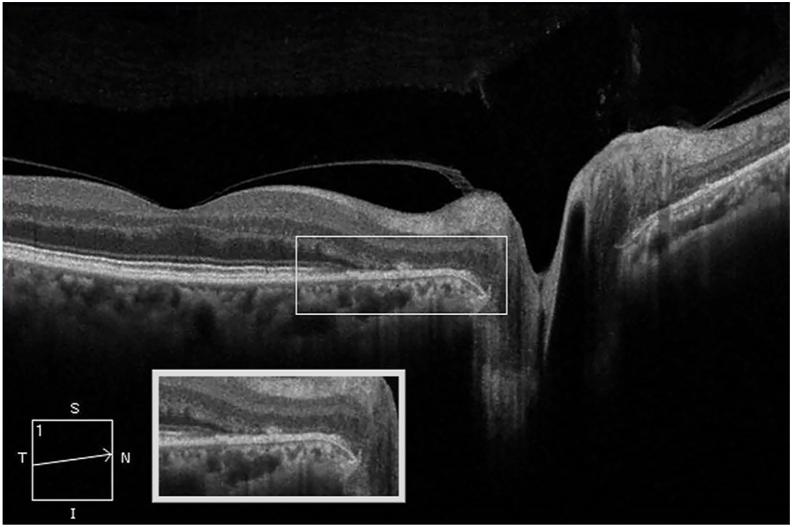
https://cdn.ncbi.nlm.nih.gov/pmc/blobs/8f07/7554322/3389589e8705/gr4.jpg

流感疫苗接种后急性特发性盲点扩大综合征
Acute idiopathic blind spot enlargement syndrome following influenza vaccination.
作者信息
Quinones Xavier, Ortiz Jan, Santos Carmen, Oliver Armando L, Rodríguez Julio
机构信息
Department of Ophthalmology, University of Puerto Rico School of Medicine, Medical Sciences Campus, San Juan, PR, 00921, USA.
出版信息
Am J Ophthalmol Case Rep. 2020 Sep 29;20:100949. doi: 10.1016/j.ajoc.2020.100949. eCollection 2020 Dec.
PURPOSE
To report a case of acute idiopathic blind spot enlargement syndrome (AIBSES) following influenza vaccination.
OBSERVATIONS
A 57-year old woman presented with a one-month history of photopsia, temporal visual field disturbance on the right eye, 11 days following the administration of the influenza virus vaccine. Visual acuity was 20/30, and color vision remained normal. Examination revealed mild venular dilation at the edge of the right optic disk and was otherwise unremarkable. Visual field testing revealed enlargement of the right physiological blind spot. Medical workup, including brain CT scan, brain MRI, RPR, antibodies, Chest X-Ray, ANA, and PPD testing, was found within normal limits. Ancillary testing was compatible with an assessment of AIBSES secondary to influenza virus vaccination.
CONCLUSIONS AND IMPORTANCE
Although direct causation may not be absolutely established by a single report, our case suggests that the influenza virus vaccine may serve as an immunological trigger for some cases of AIBSES. Thoughtful vaccination history is of the utmost importance when evaluating patients with AIBSES, as it may help elucidate the underlying precipitating factor. To our knowledge, this is the first reported case of AIBSES following influenza virus vaccination.
目的
报告1例流感疫苗接种后发生急性特发性盲点扩大综合征(AIBSES)的病例。
观察结果
一名57岁女性在接种流感病毒疫苗11天后出现为期1个月的闪光感及右眼颞侧视野障碍。视力为20/30,色觉正常。检查发现右眼视盘边缘轻度静脉扩张,其他未见明显异常。视野检查显示右眼生理盲点扩大。包括脑部CT扫描、脑部MRI、快速血浆反应素试验(RPR)、抗体、胸部X线、抗核抗体(ANA)及结核菌素试验(PPD)在内的医学检查均在正常范围内。辅助检查结果符合对流感病毒疫苗接种继发AIBSES的评估。
结论与意义
虽然单一报告可能无法绝对确定直接因果关系,但我们的病例提示流感病毒疫苗可能是某些AIBSES病例的免疫触发因素。在评估AIBSES患者时,详细了解疫苗接种史至关重要,因为这可能有助于阐明潜在的诱发因素。据我们所知,这是首例报告的流感病毒疫苗接种后发生AIBSES的病例。